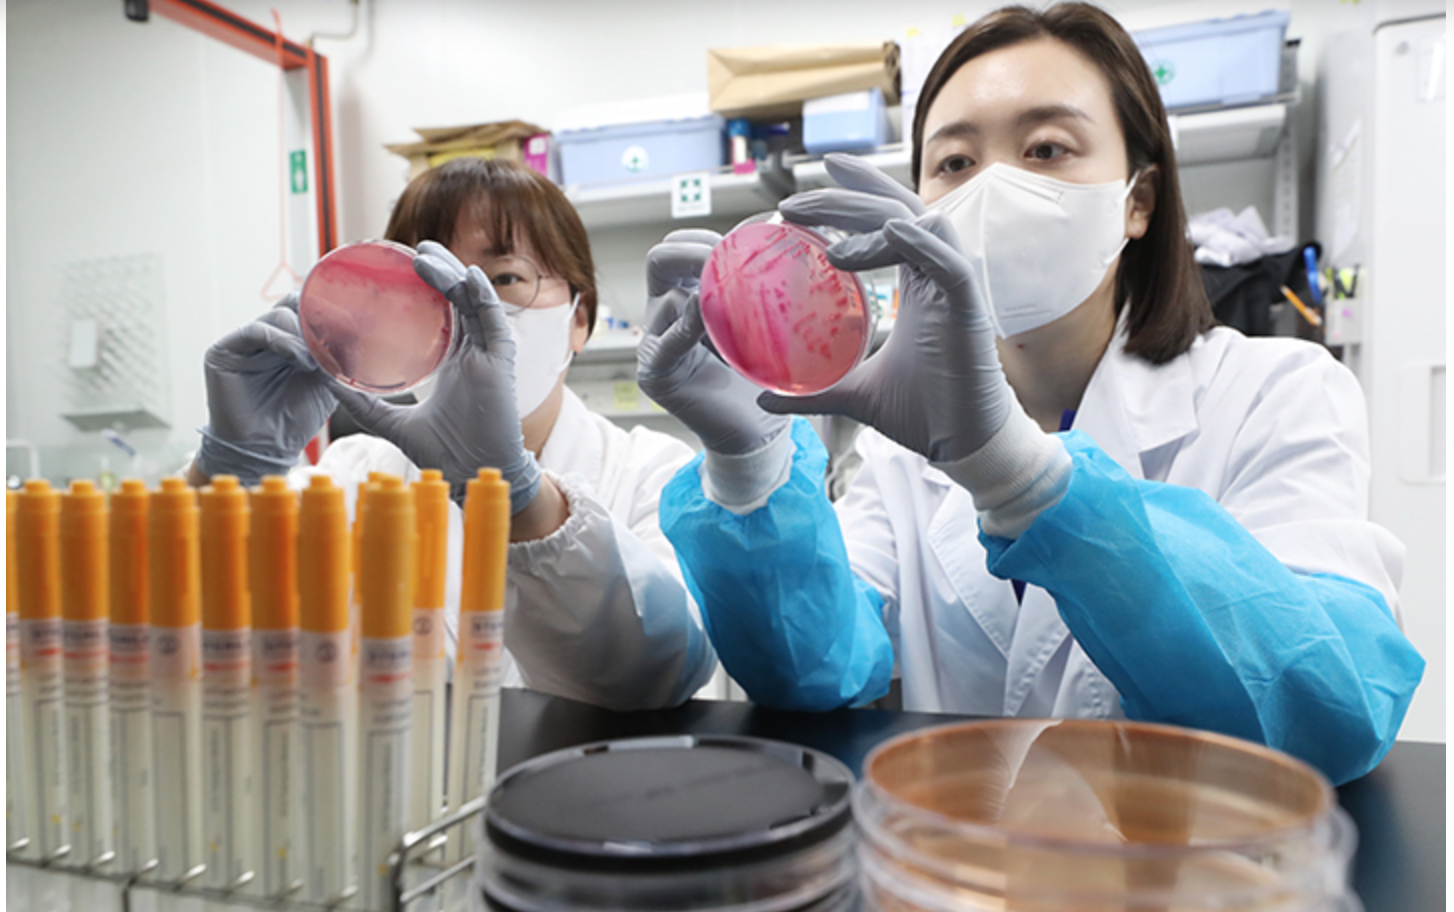

여름철 기온이 급격히 올라가면서 살모넬라 식중독 위험이 커지고 있습니다.
특히 계란이나 닭고기 같은 가금류 식품은 대표적인 감염 경로인데요.
잘못된 보관이나 조리로 인해 가정에서도 쉽게 식중독 사고가 발생할 수 있습니다.
이 글에서는 살모넬라 식중독의 증상과 원인을 정리하고, 달걀을 안전하게 보관하고 조리하는 방법까지 실생활 중심으로 정리해드립니다.
여름철 건강을 지키기 위해 꼭 알아야 할 정보, 지금부터 시작합니다!

1. 살모넬라 식중독 증상은 어떻게 나타날까?
살모넬라균에 감염되면 섭취 후 6~72시간 이내에 증상이 나타납니다.
- 주요 증상: 고열, 복통, 구토, 설사, 두통
- 지속 기간: 평균 4~7일, 어린이·노약자는 탈수 위험이 큼
특히 여름철에는 살모넬라균이 급격히 증식하기 쉬운 환경이기 때문에 조금만 관리 소홀해도 감염될 수 있습니다.
관련자료: 여름철 ‘살모넬라 식중독’ 비상…달걀 이렇게 보관해야 (건강신문)
여름철 ‘살모넬라 식중독’ 비상…주원인 달걀 ‘이렇게’ 보관하고 먹어야 - 헬스경향
연일 고온다습한 날씨가 지속되면서 살모넬라 식중독 발생위험이 커지고 있다. 살모넬라는 기온이 높은 여름철 식중독을 일으키는 균으로 덥고 습한 날씨에 빠르게 증식한다.실제로 최근 5년간
www.k-health.com



2. 손씻기·분리조리·가열, 기본만 지켜도 90% 예방
살모넬라 식중독은 생활 속 위생 수칙만 잘 지켜도 대부분 예방이 가능합니다.
- 손 씻기: 계란 만진 뒤엔 비누로 30초 이상 손씻기
- 조리도구 분리: 날달걀과 채소·과일 도마는 따로 사용
- 충분히 익히기: 중심온도 75℃ 이상, 최소 1분 이상 가열
관련자료: 농민신문 - ‘손보구가세’ 수칙으로 식중독 예방
특히 여름철 도시락이나 캠핑용 식재료는 실온에 두는 시간이 길어져 위험합니다. 날계란 요리는 피하고, 조리 후 즉시 섭취하는 것이 좋습니다.
“달걀은 충분히 익혀 드세요”…살모넬라균 주의
달걀을 구입할 때는 소비기한을 확인하고, 구입 후에는 보관 온도를 지켜 짧은 기간에 소비해야 한다. 달걀을 조리할 때는 손을 꼼꼼히 씻고 75℃에서 1분 이상 충분히 가열해야 한다. 11일 식품
www.nongmin.com



3. 여름철 달걀 보관 꿀팁 – 냉장 보관은 필수입니다
달걀을 보관할 땐 다음 사항을 꼭 지켜주세요:
- 냉장 보관 (5℃ 이하): 구매 즉시 냉장, 다른 식품과 접촉 금지
- 금 간 달걀은 폐기: 세균 침투 우려
- 야외 보관 시: 아이스박스로 10℃ 이하 유지
실온에 오래 방치할 경우 달걀 껍데기 표면에 수분이 응결되며 세균이 증식할 수 있으므로 주의하세요.



마무리 요약
- 증상: 고열, 구토, 설사 등 → 장염과 유사
- 예방법: 손씻기, 조리도구 분리, 충분한 가열
- 달걀 보관: 냉장 필수, 실온 방치 금지
올여름, 식중독 걱정 없이 건강한 식사를 위해 위 내용을 꼭 기억해 주세요!
▶ 더 자세한 정보는 영상으로도 확인해보세요: 살모넬라 식중독 예방법 – 달걀 보관 수칙 (YouTube)